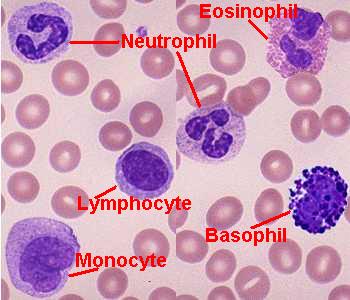

Tissues are groups of cells with a common structure and function.
- ANIMAL TISSUES
- Epithelial cells are closely joined.

- p. 78 Connective tissue bind and support other tissues, and contains sparsely
packed cells scattered through an extracellular matrix.

- p. 81 Muscle tissue is composed of long cells capable of contracting in response to nerve signals.

Humans have three types of muscle tissue.
- Skeletal muscle have striated, multinulceated fibers, and are involved in voluntary movement.
- Cardiac muscle have intercalated discs between striated cells, and are involved in involuntary contraction of the heart.
- Smooth muscle have unstriated, spindle-shaped cells, and are involved in involuntary contraction of internal organs other than the heart.
- p. 82 Nervous tissue senses stimuli and transmits signals throughout the animal.

- Epithelial cells are closely joined.
 Frog skin |
 Compact bone |
 Spongy bone |
 Adipose tissue |
Human blood |
 Nervous tissue |
 Skeletal muscle (striated, multinulceated) |
 Smooth muscle (unstriated, tapered) |
 Cardiac muscle (striated, intercalated discs) |


